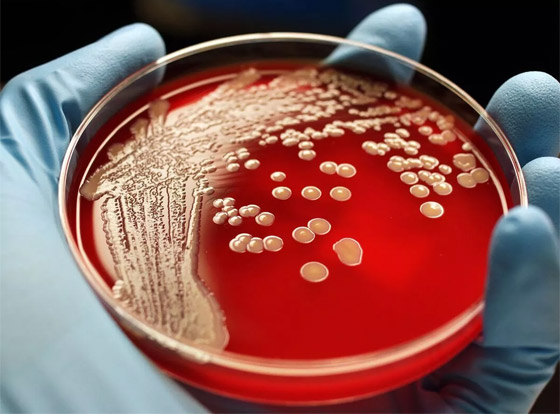
البكتيريا الخارقة.. مرض يهدد بقتل الملايين سنويا بحلول 2050 صورة رقم 2

آلام الأذن التي تعاني منها سينثيا هورتون هي بمثابة كابوس. وقالت هورتون: "قد أستيقظ من نومي وأنا أشعر بألمٍ فظيع، وكأنني أخضع لعملية معالجة قناة الجذر من دون تخدير". وبعد أن أضعفتها معركة دامت طوال حياتها مع داء الذئبة، تأثّر جهازها المناعي بسبب جولات متعددة من الإشعاع والعلاج الكيميائي بعد عملية جراحية خضعت لها في عام 2003 لعلاج ورم سرطاني في أذنها.
وأصبحت التهابات الأذن أمرًا طبيعيًا بالنسبة لها. وبينما تُخفَّف الالتهابات عادةً بجرعة من المضادات الحيوية، إلا أنّ البكتيريا الموجودة في أذن هورتون، البالغة من العمر 61 عامًا، أصبحت مُقاوِمة للمضادات الحيوية. وقال الأستاذ المساعد المختص في البكتيريا، والأمراض المعدية، والمناعة في جامعة "ولاية سان دييغو"، دواين روتش: "يمكن لهذه الجراثيم المقاوِمة للأدوية المتعددة التسبب في التهابات مزمنة لدى الأفراد لمدة تتراوح بين أشهر وعدة أعوام، وحتّى عقود في بعض الأحيان".

وعَرَض الأطباء علاج عدوى هورتون العام الماضي باستخدام أحد أقدم المفترسات في الطبيعة، وهي فيروسات صغيرة ثلاثية القوائم تُدعى العاثيات (phages)، مُصمَّمة للعثور على البكتيريا، ومهاجمتها، والتهامها. وتشكّل حالات العدوى المشابهة "تهديدًا عالميًا ملحًا للصحة العامة" يقتل 5 ملايين شخص في جميع أنحاء العالم، وفقًا لإحصائيات عام 2019 الصادرة عن المراكز الأمريكية لمكافحة الأمراض والسيطرة عليها (CDC).
وذكرت عالمة وبائيات الأمراض المعدية، ستيفاني ستراثدي، أن التقديرات تشير إلى أنّه "بحلول عام 2050، سيموت 10 ملايين شخص سنويًا، أي شخص واحد كل 3 ثوانٍ، بسبب عدوى بكتيريا خارقة". وتشغل ستراثدي منصب المديرة المشاركة لأول مركز متخصص للعلاج بالعاثيات في أمريكا الشمالية، وهو "مركز التطبيقات والعلاجات المبتكرة بالعاثيات"، أو IPATH، بكلية الطب في جامعة "كاليفورنيا" بسان دييغو.
ولرغبتها في العثور على حل مختلف لالتهابات الأذن المتكررة التي تعاني منها، وافقت هورتون على هذا العلاج. وشُحِنت عينات من البكتيريا المقاوِمة للأدوية لديها من عيادة طبيبها في ولاية بنسلفانيا إلى مركز IPATH بجامعة "كاليفورنيا" على أمل أن يتمكن صائدو العاثيات هناك من العثور على تطابق، ولكن ما اكتشفه العلماء بعد ذلك كان غير متوقع.
وتطابقت البكتيريا المُستَزرعة من أذن هورتون مع بكتيريا خارقة نادرة موجودة في بعض العلامات التجارية لقطرات العين التي لا تستلزم وصفة طبية، والتي كانت تؤثر سلبًا على رؤية الأفراد، وتعرّض حياتهم للخطر. وفجأة، أصبح البحث عن حل لمشكلة هورتون يحمل معنى جديد. هل ستساعد البكتيريا الموجودة بأذنها العلماء في العثور على العاثيات التي تعالج التهابات العين أيضًا؟.

طويلة الأمد ومعدية
وبدأت حالات شديدة من عدوى العين المقاوِمة للمضادات الحيوية في الظهور بمايو/آيار من عام 2022. وبحلول يناير/كانون الثاني التالي، أبلغت المراكز الأمريكية لمكافحة الأمراض والسيطرة عليها عن إصابة 50 مريضًا على الأقل في 11 ولاية بعدوى بكتيريا خارقة بعد استخدام قطرات عين خالية من المواد الحافظة.
وبحلول مايو/آيار من 2023، تفشى المرض إلى 18 ولاية، وتوفي 4 أشخاص، وفقد آخرون أعينهم، وأُصيب العشرات بالعدوى في أجزاء أخرى من الجسم. وأشارت المراكز الأمريكية لمكافحة الأمراض والسيطرة عليها إلى أنّ الجاني كان سلالة نادرة من بكتيريا "Pseudomonas aeruginosa" المقاوِمة للأدوية، والتي لم تُرصد مطلقًا في الولايات المتحدة قبل تفشيها.

ولم تستخدم هورتون قطرات العين قط، ولكن البكتيريا المُستزرعة من أذنها كانت من السلالة النادرة ذاتها. وباستخدام تلك البكتيريا، والعينات الأخرى التي أرسلتها المراكز الأمريكية لمكافحة الأمراض والسيطرة عليها، بدأ العلماء في مركز IPATH بالعمل على الفور، وتعرّفوا إلى أكثر من 12 عاثية نجحت في مهاجمة العامل المُمرض القاتل. ما هذا المخلوق الصغير الذي يستطيع الإطاحة بالبكتيريا القادرة على تحمل جميع الأدوية التي صنعها العلم الحديث؟ والأهم من ذلك، هل يمكن أن يصبح العلاج بالعاثيات لاعبًا رئيسيًا في المعركة لإنهاء أزمة الجراثيم الخارقة؟

الحرب المجهرية داخلنا
وأصبح لأعداد كبيرة من البكتيريا في العالم اليوم عدو طبيعي بفضل التطور، وهو فيروسات صغيرة تسمى العاثيات، وهي مُبرمجة وراثيًا لمهام البحث والتدمير. وصُمِّمَت كل مجموعة من العاثيات بشكلٍ فريد للعثور على نوع معين من مسببات الأمراض، ومهاجمتها، والتهامها.

وقال أستاذ علم البيئة والبيولوجيا التطورية في جامعة "ييل"، وعضو هيئة التدريس في قسم علم الأحياء الدقيقة في كلية "ييل" للطب بكونيتيكوت، بول تيرنر: "قد يتمتّع كل صنف بكتيري، أو حتّى الأنماط الوراثية داخله، بذخيرة كاملة من العاثيات التي تهاجمه باستخدام مجموعة واسعة من الأساليب لدخول الخلية البكتيرية وإِضعافها".
وبهدف التصدي للهجوم، تستخدم البكتيريا مناورات مراوغة مختلفة، مثل التخلص من جلدها الخارجي للقضاء على منافذ الالتحام التي تستخدمها العاثيات للدخول وتدمير العامل الممرض. وهذا خبر جيّد لأنّ البكتيريا المكشوفة حديثًا قد تفقد مقاومتها للمضادات الحيوية، وتصبح ضعيفة مرة أخرى ليتم التخلص منها.

ومع ذلك، تصبح العاثيات خارج الخدمة، وتفقد قدرتها على القتال. ولتحقيق أقصى قدر من النجاح، يبحث المتخصصون عن مجموعة متنوعة من العاثيات لمعالجة أنواع البكتيريا الخارقة الشديدة بشكلٍ خاص، ويقومون في بعض الأحيان بصنع مزيج من المحاربين المجهريين الذين يستطيعون مواصلة الهجوم.
مستوى جديد من العلاج بالعاثيات
ينقل علماء العاثيات الأبحاث والاكتشافات إلى مستوى جديد بالمختبرات في جميع أنحاء أمريكا، وينشغل العلماء في مختبر تيرنر بجامعة "ييل" برسم خرائط للعاثيات والمضادات الحيوية الأكثر انسجامًا مع بعضها البعض عندما يأتي الأمر لمكافحة مسببات الأمراض.

ويتحقق مختبر روتش في جامعة "ولاية سان دييغو" من استجابة الجسم المناعية للعاثيات أثناء تطوير تقنيات جديدة لتنقية العاثيات من أجل إعداد عينات للاستخدام عبر الوريد لدى المرضى. ويطوِّر عدد من المختبرات مكتبات عاثيات مخزنة بسلالات موجودة في الطبيعة ومعروفة بفعاليتها ضد مسببات أمراض معينة.
وفي ولاية تكساس الأمريكية، تأخذ منشأة تلك الخطوة إلى مستوى جديد، إذ تعمل على تسريع التطور عبر إنشاء العاثيات في المختبر. وقال الأستاذ المشارك في كلية "بايلور" للطب في مدينة هيوستن الأمريكية، أنتوني ماريسو إنه "بدلاً من الحصول على عاثيات جديدة من البيئة فحسب، لدينا مفاعل حيوي ينتج مليارات العاثيات في الوقت الفعلي".

ونشر مختبر ماريسو دراسة العام الماضي حول علاج 12 مريضًا باستخدام العاثيات المخصصة للملف البكتيري الفريد لكل مريض. وشكّلت الدراسة نجاحًا حقيقيًا، إذ تم القضاء على البكتيريا المقاوِمة للمضادات الحيوية لدى 5 مرضى، بينما أظهر العديد منهم تحسنًا في حالتهم.